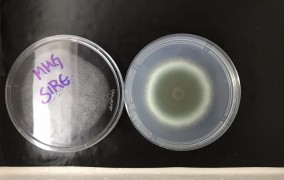

Busca - 39534 notícias encontradas
-
Papos de Física: “Little-Bangs: o princípio do universo no laboratório”
21 de agosto de 2025Nova edição de série de eventos do ICTP-SAIFR explicará o que são os “pequenos Big-Bangs” produzidos artificialmente em grandes aceleradores -
Dois editais da FAPESP atraem 247 pesquisadores residentes no exterior
21 de agosto de 2025Lançados no primeiro semestre de 2025, a Chamada Internacional para Jovens Pesquisadores e o International Thematic Grant visam atrair cientistas de alto nível para instituições de ensino e pesquisa sediadas em São Paulo -
Apresentação e Esclarecimentos da Chamada Tecnova III
21 de agosto de 2025Evento da FAPESP e da Finep vai apresentar as principais características da chamada e tirar dúvidas dos interessados em submeter propostas -
USP de São Carlos oferece curso on-line sobre aprendizado por reforço
21 de agosto de 2025Aulas abertas são direcionadas a interessados na área de aprendizado de máquina que já tenham noções básicas de cálculo e estatística; não é necessário se inscrever -
Centro de Ciências Matemáticas Aplicadas à Indústria abre vaga de pós-doutorado
20 de agosto de 2025Candidatos devem ter finalizado doutorado em ciência da computação nos últimos sete anos -
Pós-doutorado em epidemiologia e estatística na Unesp de Botucatu
20 de agosto de 2025Oportunidade requer histórico de produção intelectual nas áreas de estatística aplicada e epidemiologia de agravos à saúde do trabalhador -
Projeto Adote Online da Casa da Ciência está com inscrições abertas
20 de agosto de 2025Iniciativa tem como objetivo aproximar a ciência do público jovem por meio da criação de conteúdos educativos em vídeo -
Risco de malária na Amazônia é maior em regiões parcialmente degradadas
20 de agosto de 2025Pesquisa aponta que áreas com 50% de desmatamento próximas a locais de moradia, ou de vegetação fragmentada, permitem maior contato de mosquitos com humanos. Em meio às discussões para a COP30, estudo ajuda a entender vínculo entre destruição da floresta e avanço da doença -
Empreendedora apoiada pela FAPESP vence concurso de startups lideradas por mulheres do Brics
20 de agosto de 2025Estefânia Campos é cofundadora da empresa B.Nano Soluções Tecnológicas, que desenvolveu solução capaz de potencializar o crescimento de plantas de milho -
Contribuições para a COP30: A Interface entre o Conhecimento e a Gestão em Políticas Públicas
20 de agosto de 2025Nova edição das Conferências FAPESP 2025 debaterá a inter-relação entre a gestão pública e o conhecimento sobre as mudanças climáticas -
Introdução ao sistema Apoio à Revisão Sistemática (AReS)
20 de agosto de 2025Treinamento da USP ensinará como importar arquivos para o AReS, fazer eliminação de referências duplicadas e realizar seleção de estudos -
6º Prêmio de Inovação em Engenharia Biomédica para o SUS com inscrições abertas
20 de agosto de 2025Iniciativa tem o objetivo de buscar soluções inovadoras para o sistema público de saúde brasileiro. Inscrições até 28/08 -
Técnica permite estimar a força que atua sobre cada grão de areia de uma duna
20 de agosto de 2025Aplicações possíveis de estudo realizado na Unicamp vão do controle do assoreamento de rios e da erosão de praias a prospecções sobre a evolução da superfície de Marte -
Falta de proteína na gravidez e lactação pode comprometer viabilidade de espermatozoides
19 de agosto de 2025Pesquisa com ratos mostrou que dieta materna carente em proteína nessas fases leva a alterações na estrutura e função do epidídimo, o que explicaria prejuízos na motilidade, viabilidade e concentração espermática da prole masculina -
Projeto ARIES abre vaga de treinamento técnico em saúde pública
19 de agosto de 2025Oportunidade exige no mínimo quatro anos de experiência após a graduação e atuação comprovada na redação de materiais técnicos para apoio à gestão pública -
Pós-doutorado em planejamento ambiental e caminhabilidade na USP
19 de agosto de 2025Candidato deve possuir sólida experiência em planejamento urbano com ênfase em mobilidade ativa, com conhecimento de conforto ambiental e temas ambientais -
Doutorado profissional em gestão e desenvolvimento da educação tecnológica
19 de agosto de 2025Curso do Centro Paula Souza tem três linhas de pesquisa: “Formação do Formador”, “Gestão e Avaliação” e “Educação Tecnológica, Cultura e Sociedade”; inscrições até sábado (23/08) -
Inovação e Patentes no Brasil: Oportunidades e Desafios
19 de agosto de 2025Evento da editora Elsevier terá temas como “Ranking de Patentes na América Latina” e “Oportunidades e Desafios no Setor de Patentes no Brasil”, entre outros -
Uso de Tecnologias Digitais para a Disseminação Inclusiva e Ética de Informação em Saúde
19 de agosto de 2025Evento on-line da USP de Ribeirão Preto destacará uma nova metodologia que combina conteúdo baseado em evidências, divulgação nas redes sociais e engajamento de graduandos -
Estudo propõe avanço na matemática que permite enxergar melhor relações ocultas
19 de agosto de 2025Pesquisadores do CEPID NeuroMat usaram um modelo baseado em campos aleatórios de Markov com evolução temporal -
Ditadura brasileira e literatura: a palavra massacrada
19 de agosto de 2025Palestra da série “Encontro com os Escritores” da Universidade do Livro será apresentada por João Silvério Trevisan -
FAPESP e BBSRC apoiam intercâmbio de pesquisadores
19 de agosto de 2025Chamada Pump-Priming Award seleciona atividades de mobilidade e intercâmbio, como diárias de viagens e workshops -
Pós-doutorado em ciências ambientais e educação
18 de agosto de 2025Candidato deve ter perfil interdisciplinar voltado para a área de humanidades com ênfase em ensino e educação -
UFSCar recebe inscrições para pós-graduação em educação
18 de agosto de 2025Total de vagas é de 70 para o mestrado e 55 para doutorado, distribuídas em oito linhas de pesquisa -
Mudanças climáticas podem reduzir drasticamente a recarga de aquíferos no Brasil
18 de agosto de 2025Estudo aponta que a maioria dos reservatórios subterrâneos do país vai perder sua capacidade de renovação, aumentando o risco de escassez hídrica em diversas regiões, especialmente Sudeste e Sul. Uma estratégia para enfrentar o problema é a “recarga manejada”, que inclui técnicas para favorecer a infiltração da água de chuva ou até mesmo de esgoto tratado -
Diretriz global estabelece padrão para análise de lipídios bioativos ligados a inflamação e câncer
18 de agosto de 2025Iniciativa internacional com participação de pesquisadora do Redoxoma, um CEPID da FAPESP, aprimora a investigação de oxilipinas. Derivadas de ácidos graxos, elas desempenham papel central em processos fisiológicos e patológicos. Quantificá-las com precisão em amostras biológicas é um desafio que requer metodologia rigorosa -
Treinamento técnico em terapia de RNA em empresa com apoio PIPE
18 de agosto de 2025Projeto é desenvolvido na Mirscience Therapeutics, startup dedicada a novos tratamento de doenças ligadas ao envelhecimento -
Pesquisas sobre a Guerra do Paraguai e a Bacia do Prata na Biblioteca Brasiliana
18 de agosto de 2025Seminário na USP marca a publicação de livro que apresenta um roteiro esclarecedor das complexidades do conflito -
2º Encontro Internacional das Cidades Inteligentes às Cidades MIL
18 de agosto de 2025Evento no Instituto de Psicologia da USP propõe refletir e dialogar sobre como implementar novos modelos e visões de cidades -
Inscrições para bolsas de jornalismo científico estão abertas até 31 de agosto
18 de agosto de 2025Podem se candidatar estudantes de graduação e profissionais diplomados em qualquer área que tenham concluído ou estejam realizando um curso de introdução ao jornalismo científico
Mais lidas do mês
-
Fungo patogênico transmitido pelo arranhão do gato doméstico está presente em animais selvagens
19 de junho de 2026
-
Cientistas propõem medidas para conter avanço de fungos resistentes a medicamentos
23 de junho de 2026
-
Homens idosos que dormem mais de nove horas têm maior risco de perder mobilidade
22 de junho de 2026
-
Corpo aproveita pouco os minerais das castanhas, diz estudo que simulou a digestão humana
11 de junho de 2026
-
São Paulo terá a primeira usina do país para capturar e armazenar carbono do etanol de cana
11 de junho de 2026
-
Relógio inteligente detecta ansiedade e estresse em tempo real
08 de junho de 2026
-
O cientista brasileiro que liderou a digitalização de 400 anos de história da flora do planeta
16 de junho de 2026
-
Pesquisadoras descobrem nova espécie de microrganismo adaptado a frio e calor extremos na Antártida
01 de junho de 2026
-
Atividade física ao longo da vida reduz risco de depressão na velhice
24 de junho de 2026
-
Estudo detalha como o organismo se adapta a dietas com muita proteína e nenhum carboidrato
15 de junho de 2026